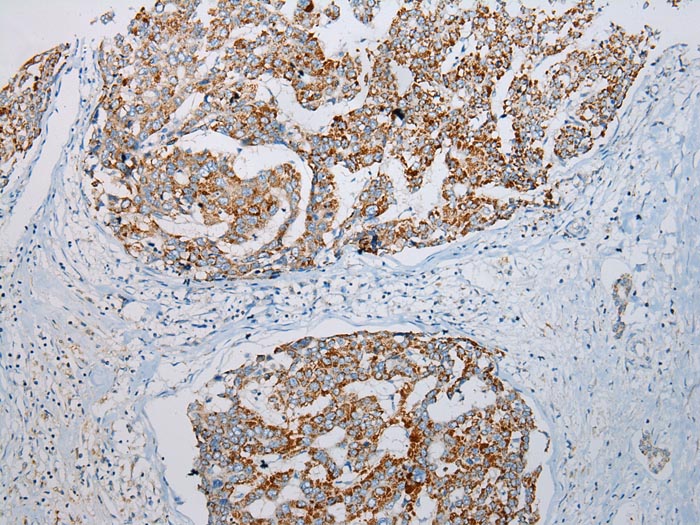
Anti-ADAMTS3 Antibody

Immunohistochemical staining of human testis shows strong cytoplasmic positivity in cells in seminiferous ducts.
Anti-ADAMTS3 Antibody
HPA021368
ApplicationsImmunoCytoChemistry, ImmunoHistoChemistry
Product group Antibodies
ReactivityHuman
TargetADAMTS3
Overview
- SupplierAtlas Antibodies
- Product NameAnti-ADAMTS3 Antibody
- Delivery Days Customer4
- ApplicationsImmunoCytoChemistry, ImmunoHistoChemistry
- CertificationResearch Use Only
- ClonalityPolyclonal
- ConjugateUnconjugated
- Gene ID9508
- Target nameADAMTS3
- Target descriptionADAM metallopeptidase with thrombospondin type 1 motif 3
- Target synonymsADAMTS-4, HKLLS3, A disintegrin and metalloproteinase with thrombospondin motifs 3, ADAM-TS 3, ADAM-TS3, ADAMTS-3, PC II-NP, a disintegrin-like and metalloprotease (reprolysin type) with thrombospondin type 1 motif, 3, procollagen II N-proteinase, procollagen II amino propeptide-processing enzyme, zinc metalloendopeptidase
- HostRabbit
- IsotypeIgG
- Protein IDO15072
- Protein NameA disintegrin and metalloproteinase with thrombospondin motifs 3
- Scientific DescriptionRecombinant Protein Epitope Signature Tag (PrEST) antigen sequence
- ReactivityHuman
- Storage Instruction-20°C,2°C to 8°C
- UNSPSC41116161